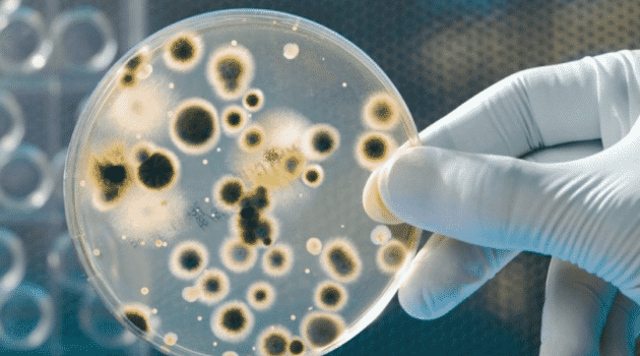
BACTERIAS QUE TRANSFORMAN EL CO2 EN COMBUSTIBLE

-
Es un instrumento de identificación con un microchip y un numero de relieve emitida por un banco, fue inventada por Alfred Bloomingdale y Frank McNamara.
Muchas personas dependen de ellas para mantener su estilo de vida ya que la mayoría de las cosas no pueden ser compradas si no es mediante la financiación por medio de tarjetas de crédito y en un futuro se reemplazara el dinero en efectivo, el mejor ejemplo: comprar bienes o servicios mediante Internet. -
Es un sistema que usa ondas electromagnéticas para medir distancias, altitudes, direcciones y velocidades de objetos estáticos o móviles, fue creado en Inglaterra por el físico Robert Watson-Watt.
Es muy importante su impacto en la sociedad ya que dando el tipo de precipitación, intensidad y dirección se puede salvaguardar vidas humanas, advertir a los medios de emergencia de lo que se les viene encima, activar alertas severas tempranas tales de huracanes o tormentas. -
Es un dispositivo electrónico usado para realizar una operación remota (o telemando) sobre una máquina.
Este aparato fue inventado en 1956 por Robert Adler y Eugene Polley, quienes trabajaban con Zenith.
Este ha tenido un impacto social muy grande en algunas personas, varias personas han llegado a la obesidad por abusar del uso de este. -
Es una maquina eléctrica utilizada para reproducir un documento en una hoja de papel normal u otra tipo de material, fue creada por Chester Floyd Carlson en Estados Unidos.
Está ha tenido un impacto social muy grande ya que es indispensable para la vida moderna y son utilizadas en empresas, negocios e instituciones de todo el mundo sino porque además es una herramienta que facilita de manera significativa el trabajo realizado en diferentes áreas y también para la organización. -
Desde Florida, la NASA lanzaba al espacio el Telstar por un cohete delta, el cual facilitaría las comunicaciones entre el continente americano y Europa. Desarrollado por la compañía norteamericana AT&T.
Los satélites artificiales han causado gran impacto en parte de las actividades desarrolladas por la humanidad. Muchas de las actividades de comunicación y entretenimiento tienen su soporte en los satélites, las señales de televisión por cable, radio y celulares son ejemplos de ello. -
Este se creó con la atención de facilitar el manejo de un entorno gráfico en una computadora, fue diseñado por Douglas Engelbart y Bill English.
El impacto que ha tenido en la sociedad ha sido muy importante ya que desde su invención nos ha facilitado el manejo de una computadora, a través de los años ha evolucionado, ha cambiado de estructura e incluso los materiales con los que se elaboran y gracias a esto podemos obtener información más fácilmente e incluso comunicarnos. -
Fue inventada por Donald Bitzer, Gene Slottow y el estudiante Robert Willson, eran monocromas de color naranja, verde o amarillo.
En la sociedad esto ha sido muy innovador y como todo entra por los ojos la mayoría de personas adquieren estas pantallas ya que tienen imágenes, sonidos, colores que entran directamente a nivel subconsciente, pero con esto se puede disfrutar de una mayor nitidez y para las actuales generaciones es algo indispensable que tienen que tener en su hogar -
Es un sistema de seguridad pasiva instalado en los automóviles modernos, fue patentado por la firma Mercedes-Benz, después de cinco años de desarrollo y pruebas del nuevo sistema.
Es muy necesaria esta implementación en nuestra sociedad porque ha mermado la mayoría de los accidentes en carretera, muertes y lesiones y ha reducido la inseguridad que puede causar algunos automóviles. -
Es un servicio de red que permite a los usuarios enviar y recibir mensajes, creado por Ray Tomlinson un ingeniero norteamericano.
Actualmente este todos los usuarios de la red, disponen de una dirección de correo electrónico y lo utiliza diariamente,en el ámbito escolar para enviar trabajos,archivos,ejercicios, en el ámbito laboral en reuniones,conferencias,para enviar facturas,cotizaciones y en el ámbito personal para comunicarse entre amigos y familiares. -
Es un conjunto descentralizado de redes de comunicación interconectadas,i nventado por Robert Kahn.
Es un invento revolucionario a la que se le atribuyen innumerables ventajas para la educación, el comercio, el entretenimiento y en ultima instancia para el desarrollo del individuo, a través de esto se puede consultar a fondo a cerca de un tema especifico y encontrar demasiadas definiciones para la acción y el resultado de informar. -
Steven J. Sasson, un ingeniero de la firma Kodak, creó en 1975 la primera cámara digital.
Tenía el tamaño de una tostadora, 0.01 megapixeles y requería 23 segundos para guardar una fotografía.
Muy distinta a las cámaras de hoy que caben en un bolsillo y fáciles de usar. -
Es la transmisión telefónica de material escaneado impreso a un número de teléfono conectado a una impresora o a otro dispositivo de salida,inventado por Alexander Bain, escocés.
Actualmente tiene un fuerte influencias mas que todo en las empresas, negocios y oficinas las cuales tienen que pasar documentos de diferentes espacios en todo el mundo, ya que es la manera mas fácil de comunicarse e imprimir un mensaje seguro a distancia, -
Es un teléfono portátil que puede hacer y recibir llamadas a través de una portadora de radiofrecuencia,fue creado Martin Cooper. Estos han tenido un impacto enorme en la sociedad, y en nuestras vidas,son una herramienta perfecta para que algunas personas puedan comunicarse con seres queridos que se encuentran a distancia, también como una herramienta educativa,pero si no los usamos de una manera adecuada cada vez nos van a perjudicar y a volver mas adictos a este aparato.
-
Es un dispositivo informático que se puede mover o transportar con relativa facilidad,fue creada por Bill Moggridge.
En la sociedad es muy efectiva ya que permite llevar información a distintas partes del mundo y no quedarse en un ordenador estático en un solo sitio, esto permitió una mayor comodidad, aunque por otro lado estar con esto todo el tiempo ha causado una relativa separación y competición en nuestra sociedad. -
Es un dispositivo para responder automáticamente llamadas telefónicas y grabar mensajes dejados por personas que llaman a un determinado número,creado por el alemán Willy Müller. Por una parte nos ha beneficiado mucho en cuanto a que hemos podido reducir el costo de llamadas.
-
Es un tipo de disco óptico para almacenamiento de datos, cambio la manera de ver películas desde una comodidad absoluta, creado por un grupo de compañías de ordenadores como Philips,Sony, Hitachi.
Impactó a todas las personas en el mundo gracias a su facilidad de uso, a que puedes saltar muchas escenas en poco tiempo y además de su facilidad de uso agregaba nuevos idiomas, subtítulos y un sin fin de nuevas acciones y opciones. -
Es un tipo de dispositivo de almacenamiento de datos que utiliza memoria flash para guardar datos e información,creada por Dov Moran y las empresas Trek Technology e IBM fueron las primeras en venderlas.
Las memorias USB destacan frente al resto por su sencillez y manejabilidad, ofrecen la capacidad de un pequeño disco duro, se transportan cómodamente en el bolsillo y se conectan al ordenador para intercambiar datos de manera simple -
Es una compañía, cuya especialización son los productos y servicios relacionados con Internet, software, dispositivos electrónicos y otras tecnologías, fue creado por Larry Page y Sergey Brin.
google es algo primordial,una práctica que se realiza constantemente: buscamos recetas, significados de palabras, restaurantes, etc. Dependemos de este buscador no sólo para nuestra vida virtual, sino también para nuestra vida diaria, ademas de su incidencia en el terreno del lenguaje. -
Es una tecnología que permite la interconexión inalámbrica de dispositivos electrónicos, abreviatura de Wireless Fidelity.
En la sociedad al ser redes inalámbricas, la comodidad que ofrecen es muy superior a las redes cableadas porque cualquiera que tenga acceso a la red puede conectarse desde distintos puntos dentro de un rango suficientemente amplio de espacio, una vez configuradas, las redes Wi-Fi permiten el acceso de múltiples ordenadores sin ningún problema ni gasto en infraestructura. -
El iPod es un reproductor de música portátil y de pequeño tamaño creado por Apple Computer. Es un reproductor de audio digital y un disco duro portátil con capacidad de 10GB, 15GB o 30GB. Este fue creado el 23 de octubre de 2001.
Su impacto fue gratificante para la mayoría delos clientes, ya que disponían de gran variedad en música, la cual podía ser escuchada mientras cumplían labores diarias. -
Hígado artificial: El Dr. Kenneth Matsumura, de la Fundación Alín, creó un dispositivo externo que, aprovechando las posibilidades de regeneración de las células del hígado. El Hígado Bio-Artificial permite que un hígado enfermo se recupere o, incluso, se sane. También sirve como puente al hígado dañado hasta que se encuentre un donante. Esta innovación del Dr. Matsumura cambió el enfoque tradicional de recrear cada una de las funciones de un hígado mediante máquinas
-
PlayStation es una familia de consolas de videojuegos desarrollada por la compañía Sony Computer Entertainment. Esta marca fue introducida en diciembre de 1994 en Japón.
Este producto tuvo un gran impacto tanto en la economía como en la industria, ya que pose un alta nivel de tecnología, lo cual complace a los clientes y su economía sigue aumentando -
El Iphone se lanzo el 29 de junio de 207 en Estados Unidos al precio de 499 dolares. Es una gran innovación tecnológica.
Su impacto es muy importante, ya no es necesario que lleves una cámara, un reloj, una calculadora, ahora todo esta en un solo dispositivo. -
Un equipo de la UCLA (universidad de California) en Los Ángeles ha logrado modificar genéticamente un microorganismo que convierte el dióxido de carbono en isobutanol 3-metil – 1-butanol, ambos de los cuales podrían ser utilizados como una fuente de combustible para automóviles o para cualquier otro motor de combustión.
-
La realidad virtual (RV) es un entorno de escenas u objetos de apariencia real. La acepción más común refiere a un entorno generado mediante tecnología informática, que crea en el usuario la sensación de estar inmerso en él. Dicho entorno es contemplado por el usuario a través de un dispositivo conocido como gafas o casco de realidad virtual. Este dispositivo fue creado en el 2015, su impacto es, segun samsung ofrece un gran potencial para modelos de negocio que viven de experiencias.
-
Un dron es un vehículo aéreo que vuela sin tripulación. Su nombre se deriva del inglés drone, que en español significa “abeja macho”. Como ya se ha mencionado, los drones se manipulan mediante un control remoto, o por medio de aplicaciones para tablets o Smartphone.Estos drones facilitan y ayudan al trabajo de los policias en cuanto a vigilancia, como medio de transporte de productos hasta monitorear ganados y cultivos.
Plan projects on a visual timeline
Map milestones, phases, deadlines, and key events in one place so the sequence is easier to see and share. Timetoast is a timeline maker for work, school, research, and stories.